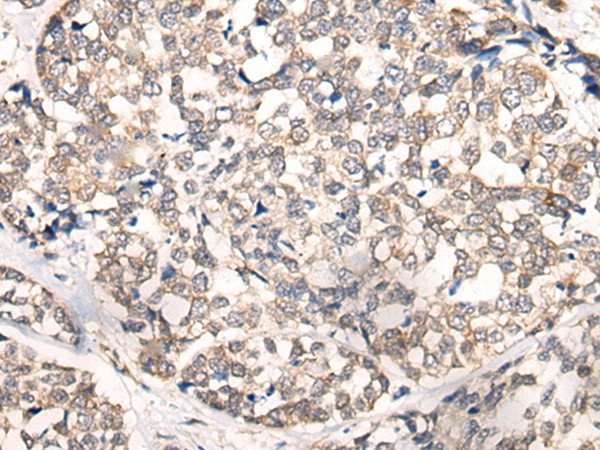
NREP Antibody in Immunohistochemistry (Paraffin) (IHC (P))

Search
Invitrogen
NREP Polyclonal Antibody
{{$productOrderCtrl.translations['antibody.pdp.commerceCard.promotion.promotions']}}
{{$productOrderCtrl.translations['antibody.pdp.commerceCard.promotion.viewpromo']}}
{{$productOrderCtrl.translations['antibody.pdp.commerceCard.promotion.promocode']}}: {{promo.promoCode}} {{promo.promoTitle}} {{promo.promoDescription}}. {{$productOrderCtrl.translations['antibody.pdp.commerceCard.promotion.learnmore']}}





Please note: We are reviewing Western blot images included in the antibody testing data in our catalog, including those provided by third parties. Unless expressly labeled or annotated as “raw-unedited”, Western blot images included in the antibody testing data in our catalog may have been edited, optimized or otherwise adjusted for presentation.
产品信息
PA5-68426
种属反应
已发表种属
宿主/亚型
分类
类型
抗原
偶联物
形式
浓度
规格
纯化类型
保存液
内含物
保存条件
运输条件
RRID
靶标信息
P311, also known as C5orf13 (chromosome 5 open reading frame 13), D4S114, PTZ17 or PRO1873, is a 68 amino acid cytoplasmic protein involved in cellular differentiation, neural function and axonal regeneration. Found in the granular layer of the cerebellum, P311 is expressed at lower levels in hippocampus, olfactory bulb, kidney, liver and heart and when expressed ectopically, P311 augments giloma motility. P311 is enriched in mice within the superficial cortical layers and striatum at E20 and the germinal zones at E17. Known to interact with Filamin 1, P311 regulates retinoic-acid lipid-droplet biogenesis, induces myofibroblast ameboid migration and the differentiation of fibroblasts into myofibroblasts. Ser-59 phosphorylation decreases P311 stability; the gene encoding P311 maps to human chromosome 5q22.1.
仅用于科研。不用于诊断过程。未经明确授权不得转售。
生物信息学
蛋白别名: Neuronal protein 3.1; Neuronal regeneration-related protein; Protein p311
基因别名: C5orf13; NREP; P311
Entrez Gene ID: (Human) 9315